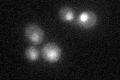
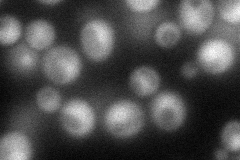
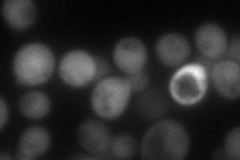
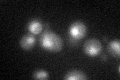

View description
Subunit of the RES complex, which is required for nuclear pre-mRNA retention and splicing; involved in bud-site selection; diploid mutants display a unipolar budding pattern instead of the wild-type bipolar pattern
Localization:
Intensity:
Fold change:
Significance:
-
C’ GFP library in SD
nucleus27.97 -
N' NOP1pr-GFP in SD
cytosol88.6359 -
N' TEF2pr-mCherry in SD
cytosol74.7823 -
N' NATIVEpr-GFP in SD

nucleus34.3315 -
N' TEF2pr-VC and Cyto-VN in SD

ambigous42.2423 -
C’ GFP library in SD+DTT
nucleus25.30.9No -
C’ GFP library in SD+H2O2

nucleus27.080.96No -
C’ GFP library in Starvation Media

nucleus20.760.74Yes -
C’ GFP library on the background of Pup2-DaMP

nucleus -
C’ GFP library on the background of CCT mutant

nucleus25.50740.911516No
